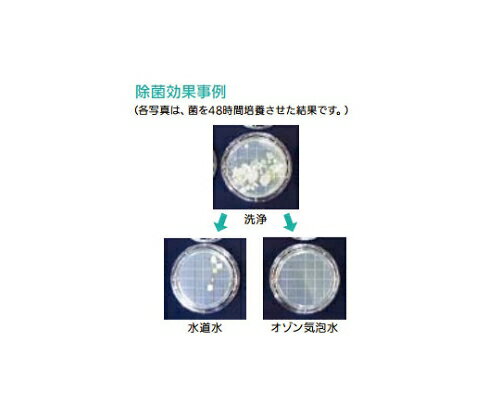
�������(AS ONE) ������ߥ����� ROZM-01 405300 ������1��

花・ガーデン・DIY
KNOWLEDGE
生活百科
|
4522件|3ページ/100ページ|
<-- 前のページへ 次のページへ --> |
![アズワン AS ONE 【別途送料】 【個人宅不可】 スクロール型ドライ真空ポンプ 20Pa 1-9199-21 [1445-0081222]](https://thumbnail.image.rakuten.co.jp/@0_mall/daishinshop/cabinet/item/1445-97/1445-0081222.jpg?_ex=64x64) 画像は代表画像です!ご購入時は商品説明等ご確認ください! アズワン AS ONE 【別途送料】 【個人宅不可】 スクロール型ドライ真空ポンプ 20Pa 1-9199-21 [1445-0081222]
画像は代表画像です!ご購入時は商品説明等ご確認ください! アズワン AS ONE 【別途送料】 【個人宅不可】 スクロール型ドライ真空ポンプ 20Pa 1-9199-21 [1445-0081222] [ショップ:DAISHIN工具箱 楽天市場店] [ショップコード:daishinshop]
価格:563,493円 税込 送料別 クレジットカード利用可 海外配送不可 翌日配送不可 ギフト包装不可
納期目安 (メーカーに在庫がある場合)13:30までにご注文の場合約3〜7日後出荷(土日祝日を除く)※表示の納期目安はあくまで目安ですのでお約束ではありません。具体的納期は都度お問い合わせください。お取り寄せ品です!ご注文後[商品欠品]及び[商品完売(廃番)]が発生する場合がございます。あらかじめご了承の上ご注文お願いいたします!またご注文の数量、お届け先によって別途送料が発生する場合がございます。その場合当店よりご連絡させていただきますのでご対応お願いいたします。商品未発送の状況でもメーカーによってはキャンセル不可となり場合もございますのでご了承の上ご注文お願いいたします。※個人宅不可!お届け先が法人様宛に限ります!●こちらの商品は条件関係なく必ず送料がかかります!※ご注文時に自動で付く送料初期設定ですので変更される可能性がございます。またご注文数量、お届け先によって追加送料発生や個人宅様可が不可になるなどの変更が起こる可能性もございます。その場合当店よりご連絡させていただきますのでご対応お願いいたします。メーカーから出荷となります!お届け先が北海道・沖縄・離島・特殊地域の場合別途送料が発生する可能性がございます!その場合当店よりご連絡させていただきますのでご対応お願いいたします。【別途送料1080円〜】【直送】【別途送料】【個人宅不可】※記載の商品画像はイメージ(代表)画像ですので画像だけの情報のみでご購入はお控え頂き、必ず記載内容をご確認下さい。・接ガス部にベアリングのない高湿ガス対応設計です。・エアーフラッシュにより水分凝縮を抑止します。・油を使用していないため、クリーンな排気が可能です。・排気速度(L/min):100/120(50/60Hz)・到達圧力(Pa):20・水蒸気処理量:≦100g/日(AF開時)・吸気口径/排気口径(内部メネジサイズ):NW25(内径ネジRc3/8)/NW16(吐出弁付き)・接ガス部材質:吸気管・排気管/ステンレス、スクロール/アルミニウム、Oリング/フッ素ゴム、Pシール/テフロン樹脂・電源:単相 100/115当社管理番号1-9199-21--検索キーワード--
![アズワン AS ONE 【別途送料】 【個人宅不可】 定量ポンプFEM 1.02FT.18S 1-5312-23 [1445-0005079]](https://thumbnail.image.rakuten.co.jp/@0_mall/daishinshop/cabinet/item/1445-4/1445-0005079.jpg?_ex=64x64) 画像は代表画像です!ご購入時は商品説明等ご確認ください! アズワン AS ONE 【別途送料】 【個人宅不可】 定量ポンプFEM 1.02FT.18S 1-5312-23 [1445-0005079]
画像は代表画像です!ご購入時は商品説明等ご確認ください! アズワン AS ONE 【別途送料】 【個人宅不可】 定量ポンプFEM 1.02FT.18S 1-5312-23 [1445-0005079] [ショップ:DAISHIN工具箱 楽天市場店] [ショップコード:daishinshop]
価格:525,653円 税込 送料別 クレジットカード利用可 海外配送不可 翌日配送不可 ギフト包装不可
納期目安 (メーカーに在庫がある場合)13:30までにご注文の場合約3〜7日後出荷(土日祝日を除く)※表示の納期目安はあくまで目安ですのでお約束ではありません。具体的納期は都度お問い合わせください。お取り寄せ品です!ご注文後[商品欠品]及び[商品完売(廃番)]が発生する場合がございます。あらかじめご了承の上ご注文お願いいたします!またご注文の数量、お届け先によって別途送料が発生する場合がございます。その場合当店よりご連絡させていただきますのでご対応お願いいたします。商品未発送の状況でもメーカーによってはキャンセル不可となり場合もございますのでご了承の上ご注文お願いいたします。※個人宅不可!お届け先が法人様宛に限ります!●こちらの商品は条件関係なく必ず送料がかかります!※ご注文時に自動で付く送料初期設定ですので変更される可能性がございます。またご注文数量、お届け先によって追加送料発生や個人宅様可が不可になるなどの変更が起こる可能性もございます。その場合当店よりご連絡させていただきますのでご対応お願いいたします。メーカーから出荷となります!お届け先が北海道・沖縄・離島・特殊地域の場合別途送料が発生する可能性がございます!その場合当店よりご連絡させていただきますのでご対応お願いいたします。【別途送料1080円〜】【直送】【別途送料】【個人宅不可】※記載の商品画像はイメージ(代表)画像ですので画像だけの情報のみでご購入はお控え頂き、必ず記載内容をご確認下さい。・特徴・メーカー3年間保証付・極微量の滴下に適していて、ジョグダイヤルにより流量をデジタルで設定できます。・18RCモデルは外部制御が可能です(18Sモデルは手動のみ)。・低騒音、低振動、自給式で、気体と液体の搬送・送液が可能です。・メンテナンスフリー、長寿命、脈動が少ないです。・メーカーでの3年間保証付きです。仕様・流量:0.03〜20mL/min・流量精度:+-2%・再現性:+-1%・タイマー設定:1秒〜99時間59秒・電源:AC100〜240V 50/60Hz・接続口径:UNF1/4-28、内径4m当社管理番号1-5312-23--検索キーワード--
![アズワン AS ONE 【別途送料】 【個人宅不可】 定量ポンプFEM 1.10FT.18S 1-1837-05 [1445-0005075]](https://thumbnail.image.rakuten.co.jp/@0_mall/daishinshop/cabinet/item/1445-4/1445-0005075.jpg?_ex=64x64) 画像は代表画像です!ご購入時は商品説明等ご確認ください! アズワン AS ONE 【別途送料】 【個人宅不可】 定量ポンプFEM 1.10FT.18S 1-1837-05 [1445-0005075]
画像は代表画像です!ご購入時は商品説明等ご確認ください! アズワン AS ONE 【別途送料】 【個人宅不可】 定量ポンプFEM 1.10FT.18S 1-1837-05 [1445-0005075] [ショップ:DAISHIN工具箱 楽天市場店] [ショップコード:daishinshop]
価格:525,653円 税込 送料別 クレジットカード利用可 海外配送不可 翌日配送不可 ギフト包装不可
納期目安 (メーカーに在庫がある場合)13:30までにご注文の場合約3〜7日後出荷(土日祝日を除く)※表示の納期目安はあくまで目安ですのでお約束ではありません。具体的納期は都度お問い合わせください。お取り寄せ品です!ご注文後[商品欠品]及び[商品完売(廃番)]が発生する場合がございます。あらかじめご了承の上ご注文お願いいたします!またご注文の数量、お届け先によって別途送料が発生する場合がございます。その場合当店よりご連絡させていただきますのでご対応お願いいたします。商品未発送の状況でもメーカーによってはキャンセル不可となり場合もございますのでご了承の上ご注文お願いいたします。※個人宅不可!お届け先が法人様宛に限ります!●こちらの商品は条件関係なく必ず送料がかかります!※ご注文時に自動で付く送料初期設定ですので変更される可能性がございます。またご注文数量、お届け先によって追加送料発生や個人宅様可が不可になるなどの変更が起こる可能性もございます。その場合当店よりご連絡させていただきますのでご対応お願いいたします。メーカーから出荷となります!お届け先が北海道・沖縄・離島・特殊地域の場合別途送料が発生する可能性がございます!その場合当店よりご連絡させていただきますのでご対応お願いいたします。【別途送料1080円〜】【直送】【別途送料】【個人宅不可】※記載の商品画像はイメージ(代表)画像ですので画像だけの情報のみでご購入はお控え頂き、必ず記載内容をご確認下さい。・特徴・メーカー3年間保証付・キャリブレーション機能により、流量の校正が容易です。・低騒音・低振動・自給式・空運転可能で容易に流量可変ができます。・18RCモデルは外部制御が可能です。・メーカーでの3年間保証付きです。仕様・流量:1〜100mL/min・再現性:+-1%・流量精度:+-2%・吸・排気接続:内径φ4mm、外径φ6mm・最大吸引揚程:3m・最大吐出揚程:60m・タイマー設定(FEM1.10KT):1秒〜99時間59秒・電源:AC100〜240V 50/60Hz・サイズ:145x93x134mm当社管理番号1-1837-05--検索キーワード--
![アズワン AS ONE 【別途送料】 【個人宅不可】 コンプレッサー 3-4(Minor) 6-1040-01 [1445-0005447]](https://thumbnail.image.rakuten.co.jp/@0_mall/daishinshop/cabinet/item/1445-4/1445-0005447.jpg?_ex=64x64) 画像は代表画像です!ご購入時は商品説明等ご確認ください! アズワン AS ONE 【別途送料】 【個人宅不可】 コンプレッサー 3-4(Minor) 6-1040-01 [1445-0005447]
画像は代表画像です!ご購入時は商品説明等ご確認ください! アズワン AS ONE 【別途送料】 【個人宅不可】 コンプレッサー 3-4(Minor) 6-1040-01 [1445-0005447] [ショップ:DAISHIN工具箱 楽天市場店] [ショップコード:daishinshop]
価格:522,133円 税込 送料別 クレジットカード利用可 海外配送不可 翌日配送不可 ギフト包装不可
納期目安 (メーカーに在庫がある場合)13:30までにご注文の場合約3〜7日後出荷(土日祝日を除く)※表示の納期目安はあくまで目安ですのでお約束ではありません。具体的納期は都度お問い合わせください。お取り寄せ品です!ご注文後[商品欠品]及び[商品完売(廃番)]が発生する場合がございます。あらかじめご了承の上ご注文お願いいたします!またご注文の数量、お届け先によって別途送料が発生する場合がございます。その場合当店よりご連絡させていただきますのでご対応お願いいたします。商品未発送の状況でもメーカーによってはキャンセル不可となり場合もございますのでご了承の上ご注文お願いいたします。※個人宅不可!お届け先が法人様宛に限ります!●こちらの商品は条件関係なく必ず送料がかかります!※ご注文時に自動で付く送料初期設定ですので変更される可能性がございます。またご注文数量、お届け先によって追加送料発生や個人宅様可が不可になるなどの変更が起こる可能性もございます。その場合当店よりご連絡させていただきますのでご対応お願いいたします。メーカーから出荷となります!お届け先が北海道・沖縄・離島・特殊地域の場合別途送料が発生する可能性がございます!その場合当店よりご連絡させていただきますのでご対応お願いいたします。【別途送料1080円〜】【直送】【別途送料】【個人宅不可】※記載の商品画像はイメージ(代表)画像ですので画像だけの情報のみでご購入はお控え頂き、必ず記載内容をご確認下さい。・特徴・低騒音でハイパワーな省エネタイプです。仕様・型番:3-4(Minor)・排気量(L/min):17/20・タンク容量(L):4・電源コード長:2m(2Pプラグ)・電源(50/60Hz):AC100V 2.7/2.8A・最高圧力:0.8MPa(0.78kgf/cm2)・復帰圧力:0.6MPa・騒音値:35dB(A)・出力(50/60Hz):0.15/0.15kW・オイル量:550mL・接続口径:PT1/4(適合チューブ/φ6.5mm)・重量:18.0kg当社管理番号6-1040-01--検索キーワード--
 (大型)オリオン RKS752J-MV-00000 小型水槽付チラー RKS752J-MV
(大型)オリオン RKS752J-MV-00000 小型水槽付チラー RKS752J-MV [ショップ:ハカルドットコム 楽天市場店] [ショップコード:e-hakaru]
価格:521,180円 税込 送料込 クレジットカード利用可 海外配送不可 翌日配送不可 ギフト包装不可
【画像はイメージです】発送日が配送予定の納期を超える場合は、別途ご相談いたします。★数量・大口割引も受付中!お問い合わせください。TEL:045-243-0716 ■小型水槽付チラー RKS752J−MVの特長 ●小さなボディながらタンク容量17L。給水口もφ100mmで大口径なのでタンク内の清掃が簡単です。 ●高精度温度制御。インバータ駆動の高圧ポンプを搭載。 ●使用温度範囲:5〜40℃(液温) ●温度精度:±0.1℃ ●冷凍機:0.75kW ●冷媒:R-410A ●冷却能力(50/60Hz):2.2/2.5kW ●加熱能力(50/60Hz):0.6/0.6kW ●冷水使用圧力:0.05〜0.3MPa ●使用最低循環量:10L/min(揚程30m) ●水槽実容量:約17L ●冷水出入口:Rc1/2 ●使用周囲温度:5〜45℃ ●外寸法・重量:W375×D500×H615mm・47kg ●消費電力(50/60Hz):1.1/1.2kW ●電源:単相200〜230V 50/60Hz ※性能は冷水温度20℃、室温25℃、圧送ポンプ循環量最大時。冷却能力は表示能力の95%以上です。 ※この他の電源仕様、オプション仕様についてはお問合せ下さい。 メーカー:オリオン機械(ORION)【画像はイメージです】発送日が配送予定の納期を超える場合は、別途ご相談いたします。★数量・大口割引も受付中!お問い合わせください。TEL:045-243-0716 ■小型水槽付チラー RKS752J−MVの特長 ●小さなボディながらタンク容量17L。給水口もφ100mmで大口径なのでタンク内の清掃が簡単です。 ●高精度温度制御。インバータ駆動の高圧ポンプを搭載。 ●使用温度範囲:5〜40℃(液温) ●温度精度:±0.1℃ ●冷凍機:0.75kW ●冷媒:R-410A ●冷却能力(50/60Hz):2.2/2.5kW ●加熱能力(50/60Hz):0.6/0.6kW ●冷水使用圧力:0.05〜0.3MPa ●使用最低循環量:10L/min(揚程30m) ●水槽実容量:約17L ●冷水出入口:Rc1/2 ●使用周囲温度:5〜45℃ ●外寸法・重量:W375×D500×H615mm・47kg ●消費電力(50/60Hz):1.1/1.2kW ●電源:単相200〜230V 50/60Hz ※性能は冷水温度20℃、室温25℃、圧送ポンプ循環量最大時。冷却能力は表示能力の95%以上です。 ※この他の電源仕様、オプション仕様についてはお問合せ下さい。 メーカー:オリオン機械(ORION)
![■トーマス 携帯用温度計検査槽〔品番:TMJ2〕【4627776:0】[送料別途見積り][法人・事業所限定][直送][店頭受取不可]](https://thumbnail.image.rakuten.co.jp/@0_mall/hcvalor-eshop/cabinet/trusco/4627/t3/trusco-4627776_t3.jpg?_ex=64x64) トーマス科学器械(株) 恒温器 ■トーマス 携帯用温度計検査槽〔品番:TMJ2〕【4627776:0】[送料別途見積り][法人・事業所限定][直送][店頭受取不可]
トーマス科学器械(株) 恒温器 ■トーマス 携帯用温度計検査槽〔品番:TMJ2〕【4627776:0】[送料別途見積り][法人・事業所限定][直送][店頭受取不可] [ショップ:ホームセンターバロー 楽天市場店] [ショップコード:hcvalor-eshop]
価格:516,560円 税込 送料別 クレジットカード利用可 海外配送不可 翌日配送不可 ギフト包装不可
《メーカー》トーマス科学器械(株)《品番》TMJ-2《特長》●液槽内に対象となる温度計やセンサーを差し込み、基準温度計や基準センサーとの比較校正を行います。●かくはん効率の良い丸形槽と強力なかくはんモーターの組み合わせにより、温度安定度は±0.05℃以内と安定した温度コントロールを行います。《用途》《仕様》●電源(V):単相100●内容量(L):2●槽内寸法(mm)幅:120●槽内寸法(mm)奥行:120●槽内寸法(mm)高さ:200●安全装置:漏電ブレーカー・槽内温度過昇防止警報●外形寸法(mm)奥行:200●外形寸法(mm)高さ:370●外形寸法(mm)幅:270●槽内寸法(mm)内径×高さ:120×200●温度範囲(℃):10〜190《仕様2》●温度調節:デジタル式温度指示調節器 PID制御方式●温度安定度:±0.05℃以内●ヒーター:シースワイヤ式 700W●撹拌機:縦型プロペラ撹拌式 3Wインダクションモーター《原産国(名称)》日本《材質/仕上》《セット内容/付属品》《注意》《JANコード》《本体質量》8.0kg※こちらの商品は送料無料対象外です。※「送料無料」と表示されても別途送料が必要となりますのでご注意ください。トーマス 携帯用温度計検査槽〔品番:TMJ-2〕[注番:4627776][本体質量:8.0kg]《包装時基本サイズ:320.00×360.00×450.00》〔包装時質量:9.0kg〕分類》研究用品》研究機器》恒温器☆納期情報:取寄管理コード(000) 掲載外商品
![アズワン AS ONE 【別途送料】 【個人宅不可】 卓上小型低温水槽 1-1587-21 [1445-0056526]](https://thumbnail.image.rakuten.co.jp/@0_mall/daishinshop/cabinet/item/1445-48/1445-0056526.jpg?_ex=64x64) 画像は代表画像です!ご購入時は商品説明等ご確認ください! アズワン AS ONE 【別途送料】 【個人宅不可】 卓上小型低温水槽 1-1587-21 [1445-0056526]
画像は代表画像です!ご購入時は商品説明等ご確認ください! アズワン AS ONE 【別途送料】 【個人宅不可】 卓上小型低温水槽 1-1587-21 [1445-0056526] [ショップ:DAISHIN工具箱 楽天市場店] [ショップコード:daishinshop]
価格:516,267円 税込 送料別 クレジットカード利用可 海外配送不可 翌日配送不可 ギフト包装不可
納期目安 (メーカーに在庫がある場合)13:30までにご注文の場合約3〜7日後出荷(土日祝日を除く)※表示の納期目安はあくまで目安ですのでお約束ではありません。具体的納期は都度お問い合わせください。お取り寄せ品です!ご注文後[商品欠品]及び[商品完売(廃番)]が発生する場合がございます。あらかじめご了承の上ご注文お願いいたします!またご注文の数量、お届け先によって別途送料が発生する場合がございます。その場合当店よりご連絡させていただきますのでご対応お願いいたします。商品未発送の状況でもメーカーによってはキャンセル不可となり場合もございますのでご了承の上ご注文お願いいたします。※個人宅不可!お届け先が法人様宛に限ります!●こちらの商品は条件関係なく必ず送料がかかります!※ご注文時に自動で付く送料初期設定ですので変更される可能性がございます。またご注文数量、お届け先によって追加送料発生や個人宅様可が不可になるなどの変更が起こる可能性もございます。その場合当店よりご連絡させていただきますのでご対応お願いいたします。メーカーから出荷となります!お届け先が北海道・沖縄・離島・特殊地域の場合別途送料が発生する可能性がございます!その場合当店よりご連絡させていただきますのでご対応お願いいたします。【別途送料1080円〜】【直送】【別途送料】【個人宅不可】※記載の商品画像はイメージ(代表)画像ですので画像だけの情報のみでご購入はお控え頂き、必ず記載内容をご確認下さい。・小型インバーターコンプレッサーを搭載していますので、高出力・低消費電力です。・型番:CBi-270B・外寸法(mm):350×455×337・槽内寸法(mm):270×210×150・温度設定範囲:−20〜+60℃・温度調節精度:±0.1℃・揚程:3.5m(MAX) ・吐出流量:4L・適正水量:8L以下 ・ヒーター:500W・冷凍機:DCブラシレスインバーター式270W(冷媒134a)・冷却能力:550W(at25℃)・安全装置:漏電/過電流ブレーカー・過熱温度ヒューズ・循環ノズル口径:外径Φ9mm ・当社管理番号1-1587-21--検索キーワード--
![アズワン AS ONE 【別途送料】 【個人宅不可】 低温循環水槽 LTC-S1400L 1-1585-03 [1445-0001262]](https://thumbnail.image.rakuten.co.jp/@0_mall/daishinshop/cabinet/item/1445-1/1445-0001262.jpg?_ex=64x64) 画像は代表画像です!ご購入時は商品説明等ご確認ください! アズワン AS ONE 【別途送料】 【個人宅不可】 低温循環水槽 LTC-S1400L 1-1585-03 [1445-0001262]
画像は代表画像です!ご購入時は商品説明等ご確認ください! アズワン AS ONE 【別途送料】 【個人宅不可】 低温循環水槽 LTC-S1400L 1-1585-03 [1445-0001262] [ショップ:DAISHIN工具箱 楽天市場店] [ショップコード:daishinshop]
価格:510,400円 税込 送料別 クレジットカード利用可 海外配送不可 翌日配送不可 ギフト包装不可
納期目安 (メーカーに在庫がある場合)13:30までにご注文の場合約3〜7日後出荷(土日祝日を除く)※表示の納期目安はあくまで目安ですのでお約束ではありません。具体的納期は都度お問い合わせください。お取り寄せ品です!ご注文後[商品欠品]及び[商品完売(廃番)]が発生する場合がございます。あらかじめご了承の上ご注文お願いいたします!またご注文の数量、お届け先によって別途送料が発生する場合がございます。その場合当店よりご連絡させていただきますのでご対応お願いいたします。商品未発送の状況でもメーカーによってはキャンセル不可となり場合もございますのでご了承の上ご注文お願いいたします。※個人宅不可!お届け先が法人様宛に限ります!●こちらの商品は条件関係なく必ず送料がかかります!※ご注文時に自動で付く送料初期設定ですので変更される可能性がございます。またご注文数量、お届け先によって追加送料発生や個人宅様可が不可になるなどの変更が起こる可能性もございます。その場合当店よりご連絡させていただきますのでご対応お願いいたします。メーカーから出荷となります!お届け先が北海道・沖縄・離島・特殊地域の場合別途送料が発生する可能性がございます!その場合当店よりご連絡させていただきますのでご対応お願いいたします。【別途送料1080円〜】【直送】【別途送料】【個人宅不可】※記載の商品画像はイメージ(代表)画像ですので画像だけの情報のみでご購入はお控え頂き、必ず記載内容をご確認下さい。・本製品は研究者・事業者向け商品です。家庭用・一般用商品ではありません。・特徴・低温恒温水槽(オープン槽)としても使用できます。・コンパクトながら冷却能力1400Wを確保しています。・外部循環流量調整バルブを内蔵していますので、バイパス配管を設けることなく外部循環量を調整する事ができます。・高さ478mmで実験台の下に納まるコンパクトタイプです。・設置場所に困らない省スペースタイプ。仕様・型番:LTC-S1400L・外部循環方式:密閉系向循環方式・使用液体種類:水・エチレングリコール水溶液・エタノール水溶当社管理番号1-1585-03--検索キーワード--
 【別途送料あり】アズワン AS 9550530PURA30ウォーターバス 【品番:4-2623-05】
【別途送料あり】アズワン AS 9550530PURA30ウォーターバス 【品番:4-2623-05】 [ショップ:住設プロ 楽天市場店] [ショップコード:jyusetsupro]
価格:509,564円 税込 送料別 クレジットカード利用可 海外配送不可 翌日配送不可 ギフト包装不可
●入数:1台 質量・質量単位 ●0.0g 【メーカー名】アズワン(株) 【メーカー品番】4-2623-05 【法人限定商品】※下記注意事項を事前にご確認ください。 ●この商品は送料が別途必要になります。 ●ご注文後、改めて当店より送料をご連絡させていただきます。送料のご了承をいただいてからの手配となります。(ご連絡までに数日かかる場合があります) ●手配後のキャンセル・返品・交換はできません。 ●メーカー直送、または、福山通運・西濃運輸・佐川急便でのお届けとなります。 ●配送業者の指定はできません。 ●原則法人宛(個人宅を除く)のみの配達となります。個人宅へのお届けの場合は事前にお問い合わせください。 ●お届け先の宛名または住所に法人名の記載がない場合は、法人であっても個人宅扱いとなります。 ●個人宅(法人名不記載を含む)へのお届けができない場合があります。 ●一部配送業者は平日のみの配達になります。原則時間指定はできません。 ●他メーカーとの同梱不可。 ●代金引換決済のご利用不可。
【AS ONE】汎用科学機器|定温・恒温機器|液相定温・恒温機器 アズワン(AS ONE) オゾンミキサー ROZM-01 405300 入数:1個
【AS ONE】汎用科学機器|定温・恒温機器|液相定温・恒温機器 アズワン(AS ONE) オゾンミキサー ROZM-01 405300 入数:1個 [ショップ:セミプロDIY店ファースト] [ショップコード:first23]
価格:505,340円 税込 送料込 クレジットカード利用可 海外配送不可 翌日配送不可 ギフト包装不可
【アズワン AS ONE】汎用科学機器 定温・恒温機器 液相定温・恒温機器 ●食器、野菜、手洗いの除菌・洗浄を簡単に。 ●壁掛方式・水道直結式。 ●水道水にオゾン気泡を混合させる装置です。 ●吐出口付近にミキシング部を設けることで、確実にオゾン気泡が水道水に混合された水を使用することが可能となり、低濃度のオゾンで効率よく除菌が行えます。 ●温水でも使用可。 商品の仕様 ●オゾン発生量(mg/h):300 ●水量(L/min):4〜12 ●電源:AC100V(50/60Hz) ●消費電力(W):32 ●サイズ(mm):280×200×150 ●質量(kg):6.5 【※ご注意ください】商品は代表の画像を使用しています。
 【AS ONE】汎用科学機器|定温・恒温機器|液相定温・恒温機器 アズワン(AS ONE) オゾンミキサー ROZM-01 405300 入数:1個
【AS ONE】汎用科学機器|定温・恒温機器|液相定温・恒温機器 アズワン(AS ONE) オゾンミキサー ROZM-01 405300 入数:1個 [ショップ:ファーストFACTORY] [ショップコード:first34]
価格:505,340円 税込 送料込 クレジットカード利用可 海外配送不可 翌日配送不可 ギフト包装不可
【アズワン AS ONE】汎用科学機器 定温・恒温機器 液相定温・恒温機器 ●食器、野菜、手洗いの除菌・洗浄を簡単に。 ●壁掛方式・水道直結式。 ●水道水にオゾン気泡を混合させる装置です。 ●吐出口付近にミキシング部を設けることで、確実にオゾン気泡が水道水に混合された水を使用することが可能となり、低濃度のオゾンで効率よく除菌が行えます。 ●温水でも使用可。 商品の仕様 ●オゾン発生量(mg/h):300 ●水量(L/min):4〜12 ●電源:AC100V(50/60Hz) ●消費電力(W):32 ●サイズ(mm):280×200×150 ●質量(kg):6.5 【※ご注意ください】商品は代表の画像を使用しています。
![アズワン AS ONE 【別途送料】 【個人宅不可】 超音波分散機 UH-50 5-4030-01 [1445-0002555]](https://thumbnail.image.rakuten.co.jp/@0_mall/daishinshop/cabinet/item/1445-2/1445-0002555.jpg?_ex=64x64) 画像は代表画像です!ご購入時は商品説明等ご確認ください! アズワン AS ONE 【別途送料】 【個人宅不可】 超音波分散機 UH-50 5-4030-01 [1445-0002555]
画像は代表画像です!ご購入時は商品説明等ご確認ください! アズワン AS ONE 【別途送料】 【個人宅不可】 超音波分散機 UH-50 5-4030-01 [1445-0002555] [ショップ:DAISHIN工具箱 楽天市場店] [ショップコード:daishinshop]
価格:504,533円 税込 送料別 クレジットカード利用可 海外配送不可 翌日配送不可 ギフト包装不可
納期目安 (メーカーに在庫がある場合)13:30までにご注文の場合約3〜7日後出荷(土日祝日を除く)※表示の納期目安はあくまで目安ですのでお約束ではありません。具体的納期は都度お問い合わせください。お取り寄せ品です!ご注文後[商品欠品]及び[商品完売(廃番)]が発生する場合がございます。あらかじめご了承の上ご注文お願いいたします!またご注文の数量、お届け先によって別途送料が発生する場合がございます。その場合当店よりご連絡させていただきますのでご対応お願いいたします。商品未発送の状況でもメーカーによってはキャンセル不可となり場合もございますのでご了承の上ご注文お願いいたします。※個人宅不可!お届け先が法人様宛に限ります!●こちらの商品は条件関係なく必ず送料がかかります!※ご注文時に自動で付く送料初期設定ですので変更される可能性がございます。またご注文数量、お届け先によって追加送料発生や個人宅様可が不可になるなどの変更が起こる可能性もございます。その場合当店よりご連絡させていただきますのでご対応お願いいたします。メーカーから出荷となります!お届け先が北海道・沖縄・離島・特殊地域の場合別途送料が発生する可能性がございます!その場合当店よりご連絡させていただきますのでご対応お願いいたします。【別途送料1080円〜】【直送】【別途送料】【個人宅不可】※記載の商品画像はイメージ(代表)画像ですので画像だけの情報のみでご購入はお控え頂き、必ず記載内容をご確認下さい。・特徴・発振機を小型化することにより省スペースを実現し、振動子も約160gと軽量です。・ハンドパルサー(手元スイッチ付き)ですので、発振機の操作無しで超音波の発振・停止ができます。・サンプルの負荷変動や圧力の変化等に対応し、一定の振幅を確保できるように出力をコントロールします。仕様・型番:UH-50・サイズ:182x320x110mm・電源:AC100V 50/60Hz 2A・出力:50W・最大振幅:40μm・周波数:20kH・振動子外寸法:φ32x297mm・3mmチップ(チタン合金製)付き当社管理番号5-4030-01--検索キーワード--
![アズワン AS ONE 【別途送料】 【個人宅不可】 ホモジナイザー 4-932-01 [1445-0067370]](https://thumbnail.image.rakuten.co.jp/@0_mall/daishinshop/cabinet/item/1445-70/1445-0067370.jpg?_ex=64x64) 画像は代表画像です!ご購入時は商品説明等ご確認ください! アズワン AS ONE 【別途送料】 【個人宅不可】 ホモジナイザー 4-932-01 [1445-0067370]
画像は代表画像です!ご購入時は商品説明等ご確認ください! アズワン AS ONE 【別途送料】 【個人宅不可】 ホモジナイザー 4-932-01 [1445-0067370] [ショップ:DAISHIN工具箱 楽天市場店] [ショップコード:daishinshop]
価格:504,533円 税込 送料別 クレジットカード利用可 海外配送不可 翌日配送不可 ギフト包装不可
納期目安 (メーカーに在庫がある場合)13:30までにご注文の場合約3〜7日後出荷(土日祝日を除く)※表示の納期目安はあくまで目安ですのでお約束ではありません。具体的納期は都度お問い合わせください。お取り寄せ品です!ご注文後[商品欠品]及び[商品完売(廃番)]が発生する場合がございます。あらかじめご了承の上ご注文お願いいたします!またご注文の数量、お届け先によって別途送料が発生する場合がございます。その場合当店よりご連絡させていただきますのでご対応お願いいたします。商品未発送の状況でもメーカーによってはキャンセル不可となり場合もございますのでご了承の上ご注文お願いいたします。※個人宅不可!お届け先が法人様宛に限ります!●こちらの商品は条件関係なく必ず送料がかかります!※ご注文時に自動で付く送料初期設定ですので変更される可能性がございます。またご注文数量、お届け先によって追加送料発生や個人宅様可が不可になるなどの変更が起こる可能性もございます。その場合当店よりご連絡させていただきますのでご対応お願いいたします。メーカーから出荷となります!お届け先が北海道・沖縄・離島・特殊地域の場合別途送料が発生する可能性がございます!その場合当店よりご連絡させていただきますのでご対応お願いいたします。【別途送料1080円〜】【直送】【別途送料】【個人宅不可】※記載の商品画像はイメージ(代表)画像ですので画像だけの情報のみでご購入はお控え頂き、必ず記載内容をご確認下さい。・様々なシャフトジェネレーターに適応しており、幅広い分野で使用することができます。・サイズ(mm):89×161×270・処理量(H2O):1〜2000mL・最高処理粘度:5000mPas・回転数:3000〜25000rpm・モーター容量:500W・支持アームサイズ:φ13×160mm・重量:3.0kg・電源:AC100〜120V 50/60Hz・防塵防水:IP30・インターフェース:USB・タイマー・カウンター機能付き・適用アクセサリー・▼スタンド:R1825(61-0005-93)・R1826(1-3当社管理番号4-932-01--検索キーワード--
![アズワン AS ONE 【別途送料】 【個人宅不可】 低温循環水槽 LTC-S1400S 1-1585-02 [1445-0001261]](https://thumbnail.image.rakuten.co.jp/@0_mall/daishinshop/cabinet/item/1445-1/1445-0001261.jpg?_ex=64x64) 画像は代表画像です!ご購入時は商品説明等ご確認ください! アズワン AS ONE 【別途送料】 【個人宅不可】 低温循環水槽 LTC-S1400S 1-1585-02 [1445-0001261]
画像は代表画像です!ご購入時は商品説明等ご確認ください! アズワン AS ONE 【別途送料】 【個人宅不可】 低温循環水槽 LTC-S1400S 1-1585-02 [1445-0001261] [ショップ:DAISHIN工具箱 楽天市場店] [ショップコード:daishinshop]
価格:498,667円 税込 送料別 クレジットカード利用可 海外配送不可 翌日配送不可 ギフト包装不可
納期目安 (メーカーに在庫がある場合)13:30までにご注文の場合約3〜7日後出荷(土日祝日を除く)※表示の納期目安はあくまで目安ですのでお約束ではありません。具体的納期は都度お問い合わせください。お取り寄せ品です!ご注文後[商品欠品]及び[商品完売(廃番)]が発生する場合がございます。あらかじめご了承の上ご注文お願いいたします!またご注文の数量、お届け先によって別途送料が発生する場合がございます。その場合当店よりご連絡させていただきますのでご対応お願いいたします。商品未発送の状況でもメーカーによってはキャンセル不可となり場合もございますのでご了承の上ご注文お願いいたします。※個人宅不可!お届け先が法人様宛に限ります!●こちらの商品は条件関係なく必ず送料がかかります!※ご注文時に自動で付く送料初期設定ですので変更される可能性がございます。またご注文数量、お届け先によって追加送料発生や個人宅様可が不可になるなどの変更が起こる可能性もございます。その場合当店よりご連絡させていただきますのでご対応お願いいたします。メーカーから出荷となります!お届け先が北海道・沖縄・離島・特殊地域の場合別途送料が発生する可能性がございます!その場合当店よりご連絡させていただきますのでご対応お願いいたします。【別途送料1080円〜】【直送】【別途送料】【個人宅不可】※記載の商品画像はイメージ(代表)画像ですので画像だけの情報のみでご購入はお控え頂き、必ず記載内容をご確認下さい。・本製品は研究者・事業者向け商品です。家庭用・一般用商品ではありません。・特徴・低温恒温水槽(オープン槽)としても使用できます。・コンパクトながら冷却能力1400Wを確保しています。・外部循環流量調整バルブを内蔵していますので、バイパス配管を設けることなく外部循環量を調整する事ができます。・スリムタイプで実験台の横に設置できます。・設置場所に困らない省スペースタイプ。仕様・型番:LTC-S1400S・外部循環方式:密閉系向循環方式・使用液体種類:水・エチレングリコール水溶液・エタノール水溶液・最大揚程:9当社管理番号1-1585-02--検索キーワード--
![アズワン AS ONE 【別途送料】 【個人宅不可】 冷却水循環装置(開放系・密閉系) 2-4922-11 [1445-0056408]](https://thumbnail.image.rakuten.co.jp/@0_mall/daishinshop/cabinet/item/1445-48/1445-0056408.jpg?_ex=64x64) 画像は代表画像です!ご購入時は商品説明等ご確認ください! アズワン AS ONE 【別途送料】 【個人宅不可】 冷却水循環装置(開放系・密閉系) 2-4922-11 [1445-0056408]
画像は代表画像です!ご購入時は商品説明等ご確認ください! アズワン AS ONE 【別途送料】 【個人宅不可】 冷却水循環装置(開放系・密閉系) 2-4922-11 [1445-0056408] [ショップ:DAISHIN工具箱 楽天市場店] [ショップコード:daishinshop]
価格:498,667円 税込 送料別 クレジットカード利用可 海外配送不可 翌日配送不可 ギフト包装不可
納期目安 (メーカーに在庫がある場合)13:30までにご注文の場合約3〜7日後出荷(土日祝日を除く)※表示の納期目安はあくまで目安ですのでお約束ではありません。具体的納期は都度お問い合わせください。お取り寄せ品です!ご注文後[商品欠品]及び[商品完売(廃番)]が発生する場合がございます。あらかじめご了承の上ご注文お願いいたします!またご注文の数量、お届け先によって別途送料が発生する場合がございます。その場合当店よりご連絡させていただきますのでご対応お願いいたします。商品未発送の状況でもメーカーによってはキャンセル不可となり場合もございますのでご了承の上ご注文お願いいたします。※個人宅不可!お届け先が法人様宛に限ります!●こちらの商品は条件関係なく必ず送料がかかります!※ご注文時に自動で付く送料初期設定ですので変更される可能性がございます。またご注文数量、お届け先によって追加送料発生や個人宅様可が不可になるなどの変更が起こる可能性もございます。その場合当店よりご連絡させていただきますのでご対応お願いいたします。メーカーから出荷となります!お届け先が北海道・沖縄・離島・特殊地域の場合別途送料が発生する可能性がございます!その場合当店よりご連絡させていただきますのでご対応お願いいたします。【別途送料1080円〜】【直送】【別途送料】【個人宅不可】※記載の商品画像はイメージ(代表)画像ですので画像だけの情報のみでご購入はお控え頂き、必ず記載内容をご確認下さい。・開放系・密閉系両方の循環が可能な卓上型低温循環恒温装置です。・小型インバーターコンプレッサー搭載により高出力でありながら省エネです。・内部循環液の残量が見える窓付きです。・型番:LTCi-400A・温度調節範囲(℃):−15〜65・温度調節精度(℃):±0.1〜±0.5・開放系循環・密閉系循環 ・冷却加熱方式:インバーターコンプレッサー270W・冷却能力:400W(at24℃) ・冷媒:R134a ・ヒーター容量:500W・電源:AC100V 50/60Hz 8.5A ・循環ノズル:ノズル外径Φ10.6当社管理番号2-4922-11--検索キーワード--
![■AS 卓上小型低温水槽CBi-270B〔品番:1158721〕【3757578:0】[送料別途見積り][法人・事業所限定][掲外取寄][店頭受取不可]](https://thumbnail.image.rakuten.co.jp/@0_mall/hcvalor-eshop/cabinet/trusco/3757/trusco-3757578.jpg?_ex=64x64) アズワン(株) 恒温器 ■AS 卓上小型低温水槽CBi-270B〔品番:1158721〕【3757578:0】[送料別途見積り][法人・事業所限定][掲外取寄][店頭受取不可]
アズワン(株) 恒温器 ■AS 卓上小型低温水槽CBi-270B〔品番:1158721〕【3757578:0】[送料別途見積り][法人・事業所限定][掲外取寄][店頭受取不可] [ショップ:ホームセンターバロー 楽天市場店] [ショップコード:hcvalor-eshop]
価格:495,660円 税込 送料別 クレジットカード利用可 海外配送不可 翌日配送不可 ギフト包装不可
《メーカー》アズワン(株)《品番》1-1587-21《特長》《用途》《仕様》《仕様2》●入数:1個《原産国(名称)》非公開《材質/仕上》《セット内容/付属品》《注意》《JANコード》4582110997686《本体質量》0.0g※こちらの商品は送料無料対象外です。※「送料無料」と表示されても別途送料が必要となりますのでご注意ください。AS 卓上小型低温水槽CBi−270B〔品番:1-1587-21〕[注番:3757578][本体質量:0.0g]《包装時基本サイズ:××》〔包装時質量:〕分類》研究用品》研究機器》恒温器☆納期情報:取寄管理コード(005) メーカー直送品 (欠品の場合有り)
![アズワン AS ONE 【個人宅不可】【別途送料】真空凍結乾燥器 VFD-03 1-6098-01 [1445-0000185]](https://thumbnail.image.rakuten.co.jp/@0_mall/daishinshop/cabinet/item/1445-1/1445-0000185.jpg?_ex=64x64) 画像は代表画像です!ご購入時は商品説明等ご確認ください! アズワン AS ONE 【個人宅不可】【別途送料】真空凍結乾燥器 VFD-03 1-6098-01 [1445-0000185]
画像は代表画像です!ご購入時は商品説明等ご確認ください! アズワン AS ONE 【個人宅不可】【別途送料】真空凍結乾燥器 VFD-03 1-6098-01 [1445-0000185] [ショップ:DAISHIN工具箱 楽天市場店] [ショップコード:daishinshop]
価格:484,587円 税込 送料込 クレジットカード利用可 海外配送不可 翌日配送不可 ギフト包装不可
納期目安 (メーカーに在庫がある場合)13:30までにご注文の場合約3〜7日後出荷(土日祝日を除く)※表示の納期目安はあくまで目安ですのでお約束ではありません。具体的納期は都度お問い合わせください。お取り寄せ品です!ご注文後[商品欠品]及び[商品完売(廃番)]が発生する場合がございます。あらかじめご了承の上ご注文お願いいたします!またご注文の数量、お届け先によって別途送料が発生する場合がございます。その場合当店よりご連絡させていただきますのでご対応お願いいたします。商品未発送の状況でもメーカーによってはキャンセル不可となり場合もございますのでご了承の上ご注文お願いいたします。※個人宅不可!お届け先が法人様宛に限ります!●こちらの商品は条件関係なく必ず送料がかかります!※ご注文時に自動で付く送料初期設定ですので変更される可能性がございます。またご注文数量、お届け先によって追加送料発生や個人宅様可が不可になるなどの変更が起こる可能性もございます。その場合当店よりご連絡させていただきますのでご対応お願いいたします。メーカーから出荷となります!お届け先が北海道・沖縄・離島・特殊地域の場合別途送料が発生する可能性がございます!その場合当店よりご連絡させていただきますのでご対応お願いいたします。【別途送料1080円〜】【直送】【別途送料】【個人宅不可】※記載の商品画像はイメージ(代表)画像ですので画像だけの情報のみでご購入はお控え頂き、必ず記載内容をご確認下さい。・本製品は研究者・事業者向け商品です。家庭用・一般用商品ではありません。・特徴・冷却水循環装置によって冷却された冷却棚で凍結状態を維持します。・冷却棚温度は冷却水循環装置でコントロールできます。仕様・外寸法(mm):380x350x520・庫内寸法(mm):300x300x285・冷却棚温度:-5度以下(冷却水温度に依存)・冷却棚寸法:200x200x10mm・真空到達度:133Pa(1Torr)・真空室材質:ステンレス(SUS304)・観測窓寸法:280x270mm・真空バルブホースニップル径:φ8mm当社管理番号1-6098-01--検索キーワード--
![アズワン AS ONE 【別途送料】 【個人宅不可】 ホモジナイザーT25デジタル 5-4040-31 [1445-0002496]](https://thumbnail.image.rakuten.co.jp/@0_mall/daishinshop/cabinet/item/1445-2/1445-0002496.jpg?_ex=64x64) 画像は代表画像です!ご購入時は商品説明等ご確認ください! アズワン AS ONE 【別途送料】 【個人宅不可】 ホモジナイザーT25デジタル 5-4040-31 [1445-0002496]
画像は代表画像です!ご購入時は商品説明等ご確認ください! アズワン AS ONE 【別途送料】 【個人宅不可】 ホモジナイザーT25デジタル 5-4040-31 [1445-0002496] [ショップ:DAISHIN工具箱 楽天市場店] [ショップコード:daishinshop]
価格:483,413円 税込 送料別 クレジットカード利用可 海外配送不可 翌日配送不可 ギフト包装不可
納期目安 (メーカーに在庫がある場合)13:30までにご注文の場合約3〜7日後出荷(土日祝日を除く)※表示の納期目安はあくまで目安ですのでお約束ではありません。具体的納期は都度お問い合わせください。お取り寄せ品です!ご注文後[商品欠品]及び[商品完売(廃番)]が発生する場合がございます。あらかじめご了承の上ご注文お願いいたします!またご注文の数量、お届け先によって別途送料が発生する場合がございます。その場合当店よりご連絡させていただきますのでご対応お願いいたします。商品未発送の状況でもメーカーによってはキャンセル不可となり場合もございますのでご了承の上ご注文お願いいたします。※個人宅不可!お届け先が法人様宛に限ります!●こちらの商品は条件関係なく必ず送料がかかります!※ご注文時に自動で付く送料初期設定ですので変更される可能性がございます。またご注文数量、お届け先によって追加送料発生や個人宅様可が不可になるなどの変更が起こる可能性もございます。その場合当店よりご連絡させていただきますのでご対応お願いいたします。メーカーから出荷となります!お届け先が北海道・沖縄・離島・特殊地域の場合別途送料が発生する可能性がございます!その場合当店よりご連絡させていただきますのでご対応お願いいたします。【別途送料1080円〜】【直送】【別途送料】【個人宅不可】※記載の商品画像はイメージ(代表)画像ですので画像だけの情報のみでご購入はお控え頂き、必ず記載内容をご確認下さい。・特徴・用途に応じて様々なシャフトジェネレーターを装着できます。 ・回転数をデジタル表示しますので再現性に優れています。 ・S25KVシリーズのシャフトを装着する事で、真空・加圧下での使用が可能です。仕様・本体・処理量(H2O):1〜2000mL・モーター容量:500W・外寸法:100x68x275mm・重量:2.5kg・電源:AC100V 50/60Hz・回転数:3000〜25000rpm・電源コード長:1.5m(2Pプラグ)・適合シャフト:S25シリーズ・型番:T25デジタル・ウルトラタラックス・※ス当社管理番号5-4040-31--検索キーワード--
 東京理化 スターラー付低温恒温槽 PSLー1400 PSL-1400 1個 ■▼177-1389 【送料都度見積】
東京理化 スターラー付低温恒温槽 PSLー1400 PSL-1400 1個 ■▼177-1389 【送料都度見積】 [ショップ:プロキュアエース] [ショップコード:asahiprocureace]
価格:481,345円 税込 送料別 クレジットカード利用可 海外配送不可 翌日配送不可 ギフト包装不可
研究用品 研究機器 -------------------------------------メーカー名東京理化器械(株)プラス名称 東京理化商品名東京理化 スターラー付低温恒温槽 PSLー1400型式PSL1400メーカー希望小売価格【税抜】470000円(税抜)オレンジブック年 ページ発注コード177-1389JANコード1特長●水槽内と試料容器内を同時に攪拌しますので、試料温度を均一に保持します。用途仕様●電源(V):100・6.7(V・A)●本体寸法(mm)幅:380●本体寸法(mm)奥行:470●本体寸法(mm)高さ:480●温度調節範囲(℃):-40〜0●温度調節精度(℃):±0.5●回転数(rpm):100〜800材質セット内容/付属品注意原産国中国重量納期目安お取寄品(都度問合せ)
![■東京理化 低温恒温水槽 NCB-2510B〔品番:266670〕【1769435:0】[送料別途見積り][法人・事業所限定][外直送][店頭受取不可]](https://thumbnail.image.rakuten.co.jp/@0_mall/hcvalor-eshop/cabinet/trusco/1769/trusco-1769435.jpg?_ex=64x64) 東京理化器械(株) 恒温器 ■東京理化 低温恒温水槽 NCB-2510B〔品番:266670〕【1769435:0】[送料別途見積り][法人・事業所限定][外直送][店頭受取不可]
東京理化器械(株) 恒温器 ■東京理化 低温恒温水槽 NCB-2510B〔品番:266670〕【1769435:0】[送料別途見積り][法人・事業所限定][外直送][店頭受取不可] [ショップ:ホームセンターバロー 楽天市場店] [ショップコード:hcvalor-eshop]
価格:480,260円 税込 送料別 クレジットカード利用可 海外配送不可 翌日配送不可 ギフト包装不可
《メーカー》東京理化器械(株)《品番》266670《特長》《用途》《仕様》●使用温度範囲(℃):-30〜80●電源(V):100●温度調整精度(℃):±0.2以下●外形寸法(mm)奥行:410(515)●外形寸法(mm)高さ:920●外形寸法(mm)幅:330(350)●水槽内容量(L):約13《仕様2》《原産国(名称)》日本《材質/仕上》《セット内容/付属品》《注意》《JANコード》《本体質量》48.0kg※こちらの商品は送料無料対象外です。※「送料無料」と表示されても別途送料が必要となりますのでご注意ください。東京理化 低温恒温水槽 NCB−2510B〔品番:266670〕[注番:1769435][本体質量:48.0kg]《包装時基本サイズ:××》〔包装時質量:〕分類》研究用品》研究機器》恒温器☆納期情報:取寄管理コード(903) 掲載外商品
| 4522件|2026-02-10更新|3ページ/100ページ
<-- 前のページへ 次のページへ --> |